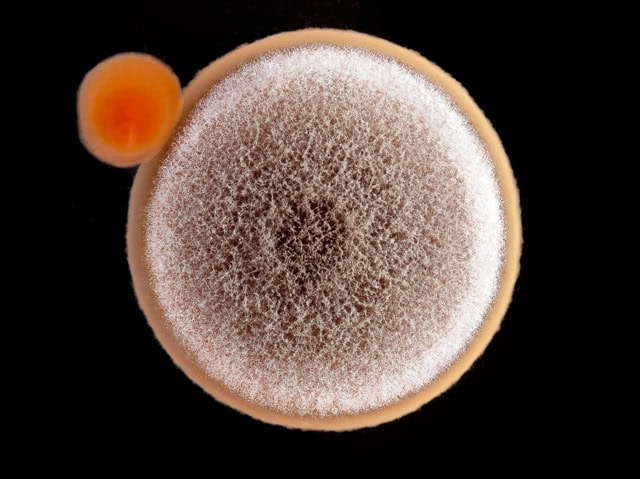
Different types of ceramic microspheres used for exterior paint

If you live in Florida, you already know how tough it is to keep your home’s exterior looking new. The hot sun, heavy humidity, salt in the air, and near-constant rain make maintaining your home’s paint feel like a never-ending cycle. You might repaint every five to seven years or sometimes sooner, only to see […]
October 28, 2025